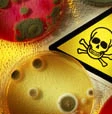
Arriva il motore a batteri

Come rendere utili i batteri, come se fossero animali per sfruttare l’energia del loro movimento. I ricercatori di Inf – Cnr (il Consiglio nazionale delle ricerche) hanno simulato sistemi di batteri in grado di trasformarsi in “motori” dal funzionamento prevedibile, costante e in grado di avviarsi senza un intervento umano. I motori batterici sono così diventato un campo di particolare interesse per la ricerca, quando fino a pochi anni fa erano una semplice curiosità. Ma dal 2006 la loto fattibilità come motori è stata dimostrata in Giappone e da allora si è aperta una nuova pagina sul loro studio. O meglio, una speranza per alimentare tutta una serie di apparecchi microscopici, come impianti micro medicali ancora tutti da inventare, per i quali i motori batterici potrebbero fornire una fonte di energia economica e di dimensioni ridottissime. Il motore batterico Un motore batterico è composto non solo da microrganismi, ma anche da due altri ingredienti: la soluzione in cui sono immersi e particolari microingranaggi in grado di mettere in movimento. Proprio da questi ultimi si progetta di estrarre energia. A scommetterci sono stati Luca Angelani, del laboratorio Smc di Infm – Cnr, e Roberto di Leonardo e Giancarlo Ruoco, del laboratorio Soft di Infm – Cnr. La soluzione consiste nell'utilizzo di microingranaggi di una particolare forma asimmetrica, con denti di lunghezze differenti e orientati nella medesima direzione, simili a stelle lievemente sbilenche. È sufficiente immergere questi ingranaggi in una soluzione di batteri, perché questi ultimi col loro movimento spontaneamente li facciano girare a velocità costante (nella simulazione, batteri di escherichia coli imprimevano ai microingranaggi una velocità costante di due giri al minuto). La somma di batteri e ingranaggi asimmetrici è l'unica vincente: particelle inanimate soggette al moto casuale non causano il movimento, e lo stesso accade per batteri al “lavoro” su ingranaggi simmetrici.